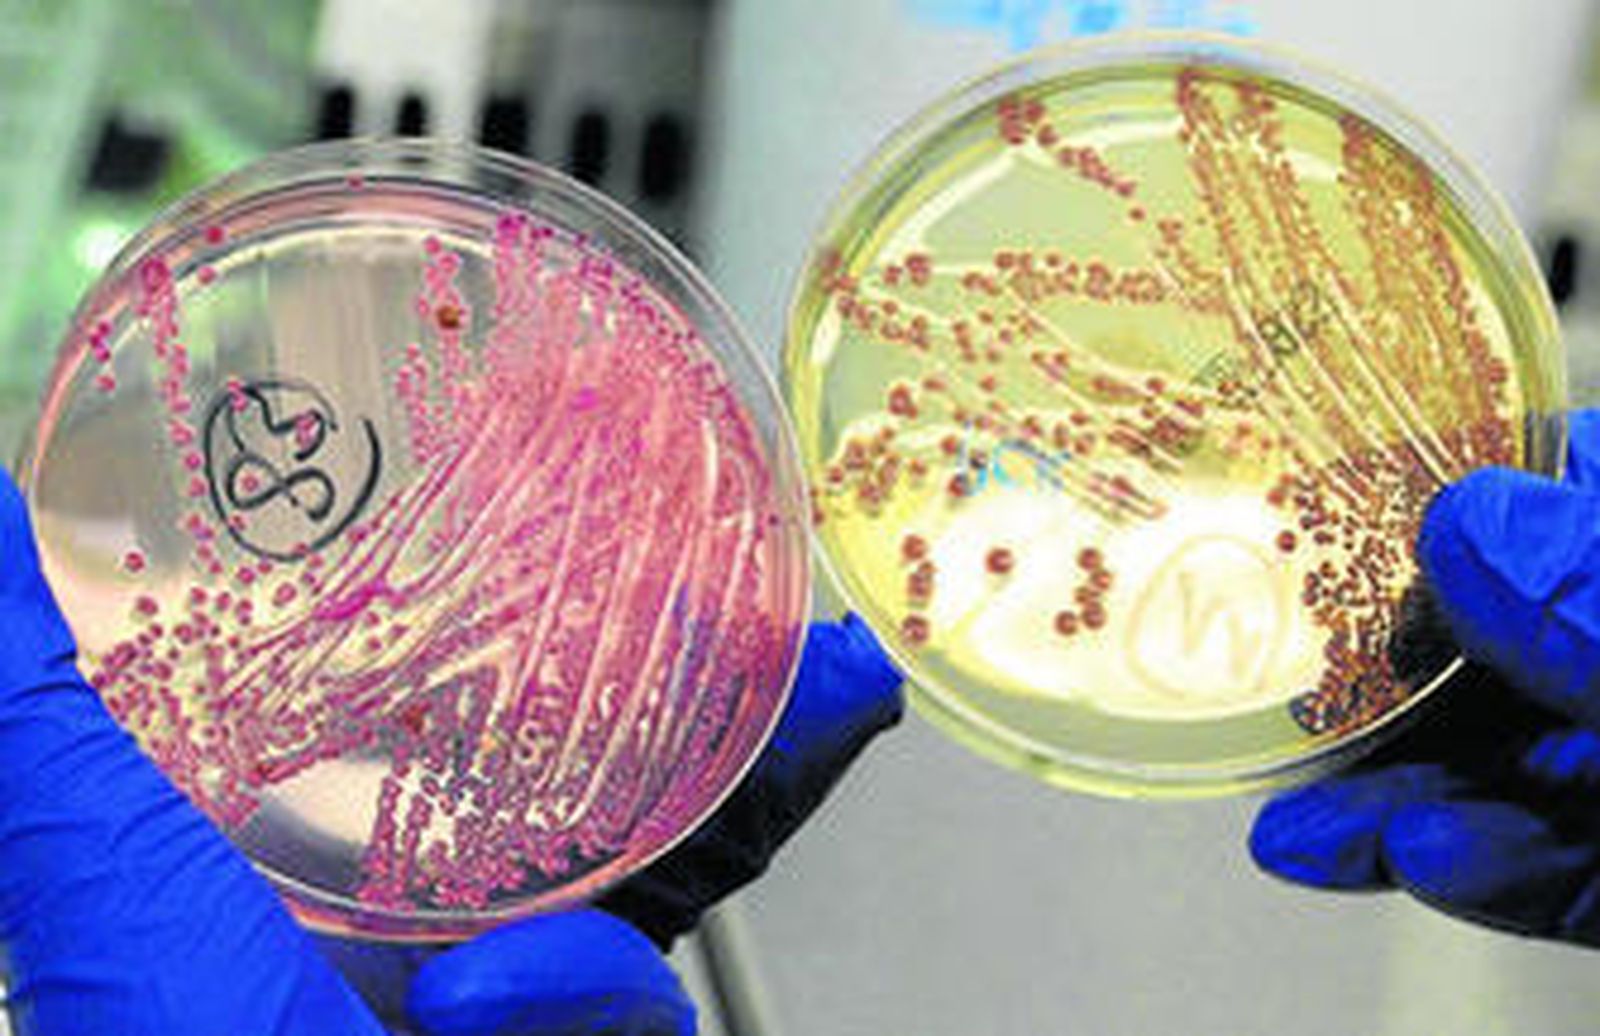
Los expertos trabajan por identificar tanto el origen de la bacteria como el foco de transmisión.

E. coli: el desafío de una bacteria
La 'Escherichia coli' habita en los intestinos de los mamíferos y es el patógeno más frecuente que produce infecciones en humanos · El microbiólogo del SAS Álvaro Pascual explica su origen y sus efectos

Europa está en alerta y pendiente del brote de E.coli desencadenado en Alemania hace una semana y que ha causado ya 17 muertes y unos 2.000 infectados. La noticia falsa de que eran los pepinos españoles, y más concretamente los andaluces, los que produjeron el brote, ha aumentado el interés de la ciudadanía por saber más sobre la bacteria. ¿De dónde viene? ¿Cómo se contagia? ¿Por qué mata? La respuesta a estas preguntas las aclara el director de la unidad de Microbiología del Hospital Virgen Macarena de Sevilla y catedrático de la universidad sevillana, Álvaro Pascual, voz autorizada por la Consejería de Salud como experto en este microorganismo.
Lo primero es definirla. La E.Coli (Escherichia coli) es una bacteria común que vive como comensal en los intestinos de animales y humanos. "De hecho, tiene una labor beneficiosa ya que es fuente de nutrientes y a los animales los ayuda por ejemplo a realizar las digestiones. Así, vive en muchos animales sin producir daño". El problema está en las cepas de esta bacteria, que es el patógeno más frecuente que produce infecciones en humanos.
Habitualmente son inofensivas pero hay algunas variedades más virulentas que pueden llegar a ser mortales. Y ese es el caso de la cepa detectada ahora en Alemania, la O104:H4, una variante poco conocida. De hecho, ayer circulaban varias versiones. Mientras la OMS dijo que era una mutación nunca antes conocida, científicos alemanes y chinos dijeron tras descifrar su genoma que es fruto de un cruce entre cepas ya conocidas más que una mutación espontánea. Un cruce que ha dejado una variante muy agresiva que es resistente a algunos antibióticos, muy tóxica y que evoluciona rápidamente hacia el fallo renal del paciente.
"Hay cepas más virulentas como la variante enterohemorrágica. Habitualmente produce infecciones con diarreas que supone un cuadro autolimitado que se cura sin antibióticos. Pero en el 5 o 10% de los casos se complica con un Síndrome Urémico Hemolítico que genera complicaciones en la sangre y en el riñón". Y esa complicación es la que ha causado las 17 muertes contabilizadas (16 en Alemania y 1 en Suecia) en este brote.
La clave es que esta bacteria, según la cepa, produce unas toxinas muy potentes que generan las complicaciones, sobre todo en personas inmunodeprimidas y niños. Pero no significa que todos los afectados por la bacteria sufran la misma complicación. No es letal en todos los casos. De hecho, en anteriores brotes los niños eran los principales afectados y en este caso hay más mujeres y mayores. "El por qué unos tiene complicaciones y otros no, no se sae bien", dice Pascual.
De estas que producen toxinas (verotoxigénicas) la más común es la 0157:H7, "que se conoce bien, pero el brote alemán es diferente. Esta cepa sí está en la base de datos de Alemania pero por ejemplo en países como España se conoce poco", comenta. Estas variantes negativas casi siempre se han asociado a la carne de vacuno de las hamburguesas (tras el brote de 0157 de EEUU en 1982), pero ahora, tras descartarse los pepinos, "cualquier alimento que haya estado en contacto con las heces de los animales puede ser el causante del brote". Sobre la posibilidad de que se extienda a otros países, "cualquier persona que viaje a Alemania y se contagie puede transmitirlo, por lo que es muy importante la higiene".
También te puede interesar
Contenido ofrecido por APDI Group
Contenido ofrecido por el Circo Encantado
Contenido ofrecido por Aguasvira











